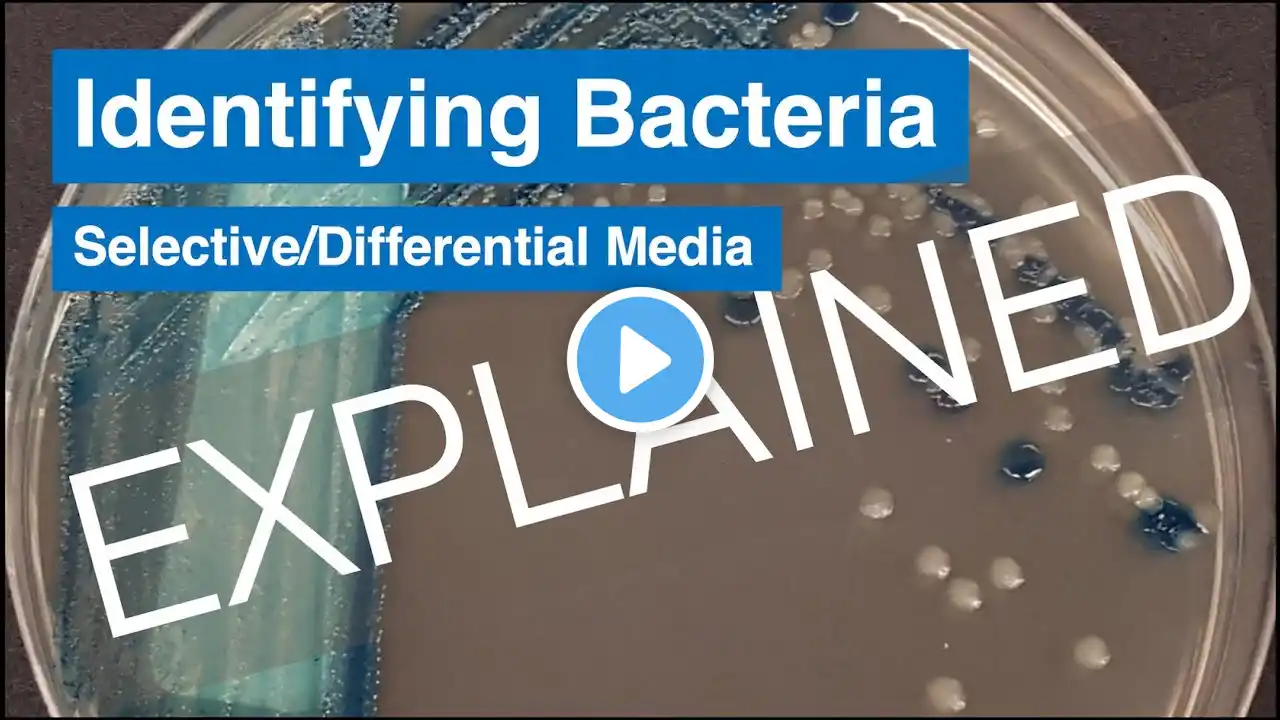
ภาพตัวอย่างวิดีโอ

Culture Media & its Types
This video contains different types of culture media with their example. #culturemedia #culturemediamicrobiology #microbiologyeasynotes The channel is for Microbiology learners and enthusiast. On this Channel one can find terms and topics related to Microbiology. Purpose of making this Channel is to make Microbiology easy to understand. So read, learn, ask and contribute. On this channel different playlists are available which contain various topics on microbiology. Please go through it. These playlists are: 1. Interesting world of microbes:- you may know interesting facts and characteristics of microbes here. 2. Microbiology Glossary:- here you will get overview of different words and terms used in microbiology. 3. Microbiology Lessons:- here you will have lessons on different topics of microbiology. Lessons are available in Hindi also. 4. Microbe News: Latest news about microbes. #microbiology #culturemedia #microbiologyeasynotes for more interesting content and news You can visit my FB page at / microbiology.en